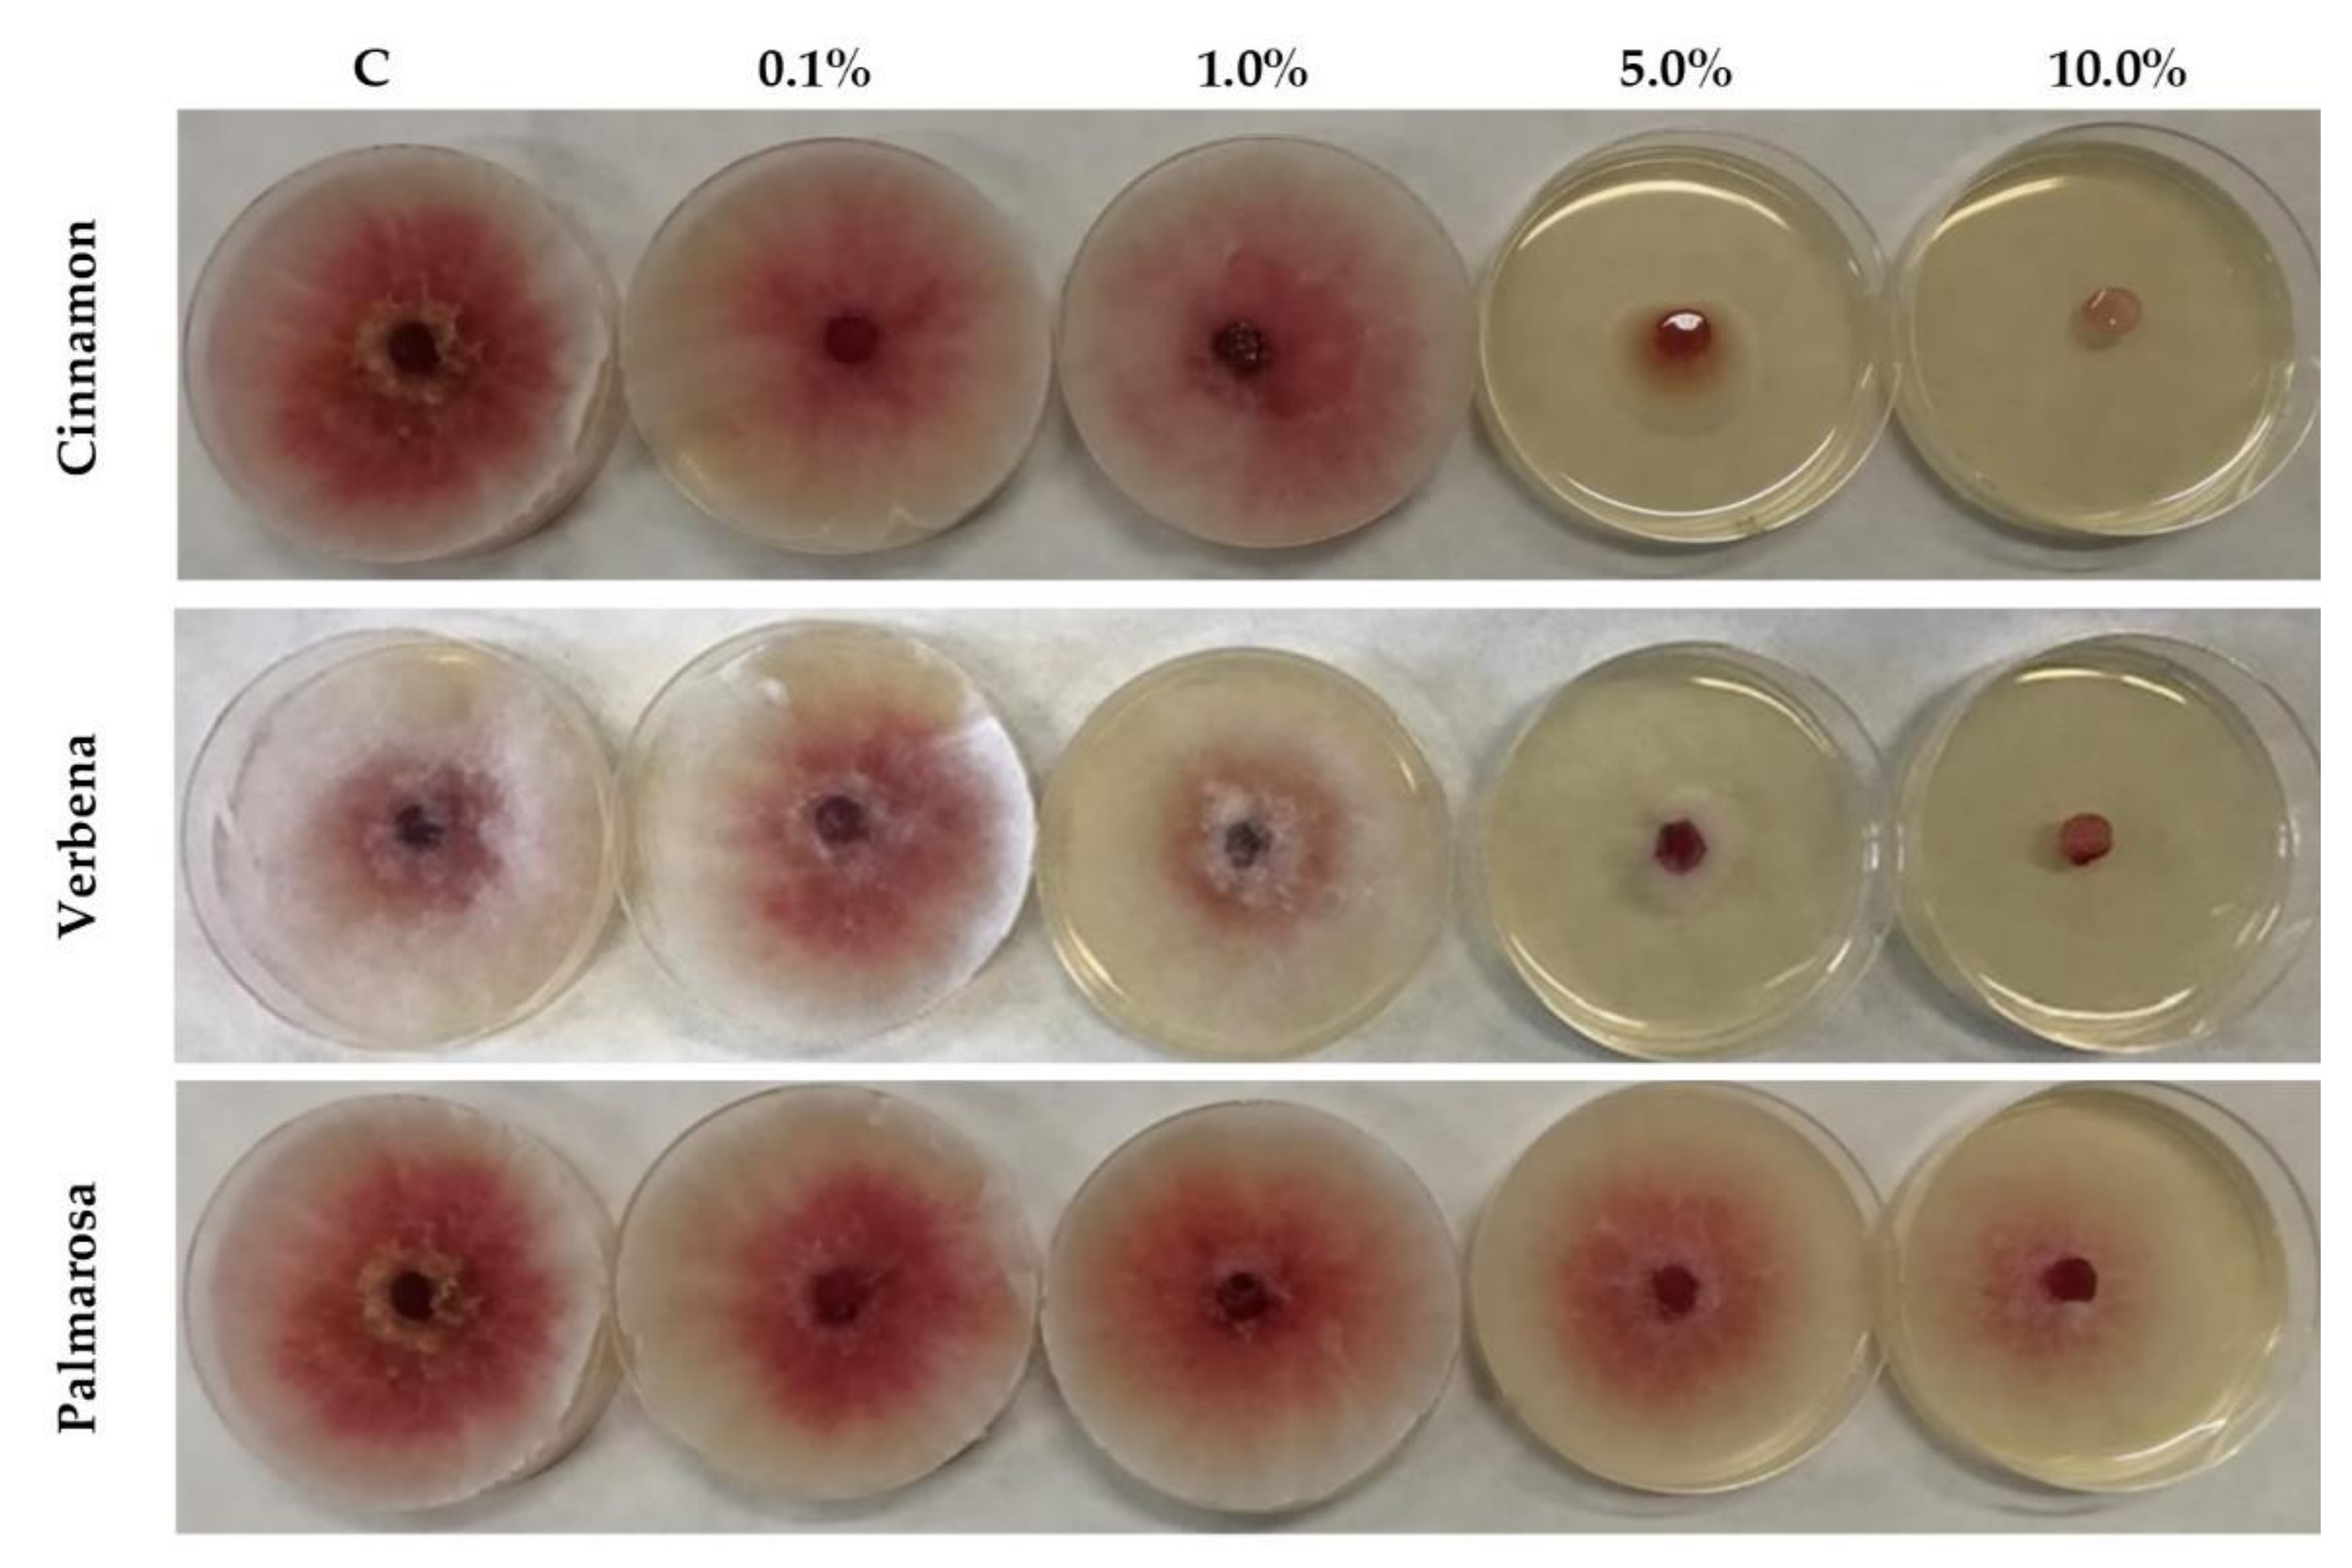
Applsci 12 00473 g001 Applsci 12 00473 g001

The Concentration-Dependent Effects of Essential Oils on the Growth of Fusarium graminearum and Mycotoxins Biosynthesis in Wheat and Maize Grain
Abstract
Featured Application
Abstract
1. Introduction
2. Materials and Methods
2.1. Plant Material
2.2. Fusarium Strain
2.3. Standards, Chemicals, and Reagents
2.4. EOs Preparations
2.5. Antifungal Activity of EOs by Disc Volatilization Method
2.6. EOs and the Growth of Fusarium and Mycotoxins Biosynthesis
2.7. Chemical Analysis
2.7.1. Ergosterol
2.7.2. Mycotoxins Analysis
2.8. Morphology Observations
2.9. Staining and Fluorescence Microscopy
2.10. Statistical Analysis
3. Results
3.1. The Inhibition of the Growth of F. graminearum Depending on the EO Concentration
3.2. Staining and Microscopy
3.3. The Effect of EO Concentration on the Growth of F. graminearum on Maize and Wheat Grain
3.4. The Effect of EO Concentration on the ZEA Level in Maize and Wheat Grain
3.5. The Effect of EO Concentration on the DON Level in Maize and Wheat Grain
4. Discussion
5. Conclusions
Supplementary Materials
Author Contributions
Funding
Institutional Review Board Statement
Informed Consent Statement
Data Availability Statement
Conflicts of Interest
References
- Shahbandeh, M. Worldwide Production of Grain in 2020/21, by Type. Statista 2021. Available online: https://www.statista.com/statistics/263977/world-grain-production-by-type/ (accessed on 24 September 2021).
- Ranum, P.; Peña-Rosas, J.P.; Garcia-Casal, M.N. Global maize production, utilization, and consumption. Ann. N. Y. Acad. Sci. 2014, 1312, 105–112. [Google Scholar] [CrossRef] [PubMed]
- Deepa, N.; Nagaraja, H.; Sreenivasa, M.Y. Prevalence of fumonisin producing Fusarium verticillioides associated with cereals grown in Karnataka (India). Food Sci. Hum. Wellness 2016, 5, 156–162. [Google Scholar] [CrossRef][Green Version]
- Ferreira, F.M.D.; Hirooka, E.Y.; Ferreira, F.D.; Silva, M.V.; Mossini, S.A.G.; Machinski, M., Jr. Effect of Zingiber officinale Roscoe essential oil in fungus control and deoxynivalenol production of Fusarium graminearum Schwabe in vitro. Food Addit. Contam. Part A 2018, 35, 2168–2174. [Google Scholar] [CrossRef]
- Lofgren, L.; Riddle, J.; Dong, Y.; Kuhnem, P.R.; Cummings, J.A.; Del Ponte, E.M.; Bergstrom, G.C.; Kistler, H.C. A high proportion of NX-2 genotype strains are found among Fusarium graminearum isolates from northeastern New York State. Eur. J. Plant Pathol. 2018, 150, 791–796. [Google Scholar] [CrossRef]
- Karlovsky, P. Biological detoxification of the mycotoxin deoxynivalenol and its use in genetically engineered crops and feed additives. Appl. Microbiol. Biotechnol. 2011, 91, 491–504. [Google Scholar] [CrossRef] [PubMed]
- Dweba, C.C.; Figlan, S.; Shimelis, H.A.; Motaung, T.E.; Sydenham, S.; Mwadzingeni, L.; Tsilo, T.J. Fusarium head blight of wheat: Pathogenesis and control strategies. Crop Prot. 2017, 91, 114–122. [Google Scholar] [CrossRef]
- Palacios, S.A.; Erazo, J.G.; Ciasca, B.; Lattanzio, V.M.T.; Reynoso, M.M.; Farnochi, M.C.; Torres, A.M. Occurrence of deoxynivalenol and deoxynivalenol-3-glucoside in durum wheat from Argentina. Food Chem. 2017, 230, 728–734. [Google Scholar] [CrossRef]
- Escrivá, L.; Font, G.; Manyes, L. In vivo toxicity studies of fusarium mycotoxins in the last decade: A review. Food Chem. Toxicol. 2015, 78, 185–206. [Google Scholar] [CrossRef]
- Kelly, A.C.; Clear, R.M.; O’Donnell, K.; McCormick, S.; Turkington, T.K.; Tekauz, A.; Gilbert, J.; Kistler, H.C.; Busman, M.; Ward, T.J. Diversity of Fusarium head blight populations and trichothecene toxin types reveals regional differences in pathogen composition and temporal dynamics. Fungal Genet. Biol. 2015, 82, 22–31. [Google Scholar] [CrossRef]
- Martínez-Romero, D.; Serrano, M.; Bailén, G.; Guillén, F.; Zapata, P.J.; Valverde, J.M.; Castillo, S.; Fuentes, M.; Valero, D. The use of a natural fungicide as an alternative to preharvest synthetic fungicide treatments to control lettuce deterioration during postharvest storage. Postharvest Biol. Technol. 2008, 47, 54–60. [Google Scholar] [CrossRef]
- Boukaew, S.; Prasertsan, P.; Sattayasamitsathit, S. Evaluation of antifungal activity of essential oils against aflatoxigenic Aspergillus flavus and their allelopathic activity from fumigation to protect maize seeds during storage. Ind. Crops Prod. 2017, 97, 558–566. [Google Scholar] [CrossRef]
- Sumalan, R.M.; Alexa, E.; Popescu, I.; Negrea, M.; Radulov, I.; Obistioiu, D.; Cocan, I. Exploring Ecological Alternatives for Crop Protection Using Coriandrum sativum Essential Oil. Molecules 2019, 24, 2040. [Google Scholar] [CrossRef] [PubMed]
- Tongnuanchan, P.; Benjakul, S. Essential Oils: Extraction, Bioactivities, and Their Uses for Food Preservation. J. Food Sci. 2014, 79, R1231–R1249. [Google Scholar] [CrossRef] [PubMed]
- Fornari, T.; Vicente, G.; Vázquez, E.; García-Risco, M.R.; Reglero, G. Isolation of essential oil from different plants and herbs by supercritical fluid extraction. J. Chromatogr. A 2012, 1250, 34–48. [Google Scholar] [CrossRef]
- Ayvaz, A.; Sagdic, O.; Karaborklu, S.; Ozturk, I. Insecticidal Activity of the Essential Oils from Different Plants Against Three Stored-Product Insects. J. Insect Sci. 2010, 10, 1–13. [Google Scholar] [CrossRef] [PubMed]
- Bertuzzi, G. Antioxidative Action of Citrus limonum Essential Oil on Skin. Eur. J. Med. Plants 2013, 3, 1–9. [Google Scholar] [CrossRef]
- Properzi, A.; Angelini, P.; Venanzoni, R. Some Biological Activities of Essential Oils. Med. Aromat. Plants 2013, 2, 1000136. [Google Scholar] [CrossRef]
- Prakash, B.; Kedia, A.; Mishra, P.K.; Dubey, N.K. Plant essential oils as food preservatives to control moulds, mycotoxin contamination and oxidative deterioration of agri-food commodities—Potentials and challenges. Food Control 2015, 47, 381–391. [Google Scholar] [CrossRef]
- Gakuubi, M.M.; Maina, A.W.; Wagacha, J.M. Antifungal Activity of Essential Oil of Eucalyptus camaldulensis Dehnh. against Selected Fusarium spp. Int. J. Microbiol. 2017, 2017. [Google Scholar] [CrossRef]
- Sharma, A.; Rajendran, S.; Srivastava, A.; Sharma, S.; Kundu, B. Antifungal activities of selected essential oils against Fusarium oxysporum f. sp. lycopersici 1322, with emphasis on Syzygium aromaticum essential oil. J. Biosci. Bioeng. 2017, 123, 308–313. [Google Scholar] [CrossRef]
- Roselló, J.; Sempere, F.; Sanz-Berzosa, I.; Chiralt, A.; Santamarina, M.P. Antifungal activity and potential use of essential oils against Fusarium culmorum and Fusarium verticillioides. J. Essent. Oil-Bear. Plants 2015, 18, 359–367. [Google Scholar] [CrossRef]
- Kalagatur, N.K.; Nirmal Ghosh, O.S.; Sundararaj, N.; Mudili, V. Antifungal Activity of Chitosan Nanoparticles Encapsulated With Cymbopogon martinii Essential Oil on Plant Pathogenic Fungi Fusarium graminearum. Front. Pharmacol. 2018, 9, 610. [Google Scholar] [CrossRef] [PubMed]
- Soylu, E.M.; Soylu, S.; Kurt, S. Antimicrobial activities of the essential oils of various plants against tomato late blight disease agent Phytophthora infestans. Mycopathologia 2006, 161, 119–128. [Google Scholar] [CrossRef] [PubMed]
- Perumal, A.B.; Sellamuthu, P.S.; Nambiar, R.B.; Sadiku, E.R. Antifungal activity of five different essential oils in vapour phase for the control of Colletotrichum gloeosporioides and Lasiodiplodia theobromae in vitro and on mango. Int. J. Food Sci. Technol. 2016, 51, 411–418. [Google Scholar] [CrossRef]
- Brul, S.; Nussbaum, J.; Dielbandhoesing, S.K. Fluorescent probes for wall porosity and membrane integrity in filamentous fungi. J. Microbiol. Methods 1997, 28, 169–178. [Google Scholar] [CrossRef]
- Chitarra, G.S.; Breeuwer, P.; Nout, M.J.R.; Van Aelst, A.C.; Rombouts, F.M.; Abee, T. An antifungal compound produced by Bacillus subtilis YM 10–20 inhibits germination of Penicillium roqueforti conidiospores. J. Appl. Microbiol. 2003, 94, 159–166. [Google Scholar] [CrossRef] [PubMed]
- Perczak, A.; Gwiazdowska, D.; Marchwińska, K.; Juś, K.; Gwiazdowski, R.; Waśkiewicz, A. Antifungal activity of selected essential oils against Fusarium culmorum and F. graminearum and their secondary metabolites in wheat seeds. Arch. Microbiol. 2019, 201, 1085–1097. [Google Scholar] [CrossRef]
- Perczak, A.; Gwiazdowska, D.; Gwiazdowski, R.; Juś, K.; Marchwińska, K.; Waśkiewicz, A. The Inhibitory Potential of Selected Essential Oils on Fusarium spp. Growth and Mycotoxins Biosynthesis in Maize Seeds. Pathogens 2020, 9, 23. [Google Scholar] [CrossRef]
- Breeuwer, P.; Drocourt, J.L.; Bunschoten, N.; Zwietering, M.H.; Rombouts, F.M.; Abee, T. Characterization of uptake and hydrolysis of fluorescein diacetate and carboxyfluorescein diacetate by intracellular esterases in Saccharomyces cerevisiae, which result in accumulation of fluorescent product. Appl. Environ. Microbiol. 1995, 61, 1614–1619. [Google Scholar] [CrossRef]
- Oparka, K.J. Uptake and compartmentation of fluorescent probes by plant cells. J. Exp. Bot. 1991, 42, 565–579. [Google Scholar] [CrossRef]
- Eskola, M.; Kos, G.; Elliott, C.T.; Hajšlová, J.; Mayar, S.; Krska, R. Worldwide contamination of food-crops with mycotoxins: Validity of the widely cited ‘FAO estimate’ of 25%. Crit. Rev. Food Sci. Nutr. 2020, 60, 2773–2789. [Google Scholar] [CrossRef]
- Chilaka, C.; De Boevre, M.; Atanda, O.; De Saeger, S. Occurrence of Fusarium Mycotoxins in Cereal Crops and Processed Products (Ogi) from Nigeria. Toxins 2016, 8, 342. [Google Scholar] [CrossRef]
- Singh, R.; Singh, G.S. Traditional agriculture: A climate-smart approach for sustainable food production. Energy Ecol. Environ. 2017, 2, 296–316. [Google Scholar] [CrossRef]
- Żmija, D. Zrównoważony rozwój rolnictwa i obszarów wiejskich w Polsce. Studia Ekon. 2014, 166, 149–158. [Google Scholar]
- Garcia, S.N.; Osburn, B.I.; Jay-Russell, M.T. One Health for Food Safety, Food Security, and Sustainable Food Production. Front. Sustain. Food Syst. 2020, 4, 1. [Google Scholar] [CrossRef]
- Patriarca, A.; Fernández Pinto, V. Prevalence of mycotoxins in foods and decontamination. Curr. Opin. Food Sci. 2017, 14, 50–60. [Google Scholar] [CrossRef]
- Čolović, R.; Puvača, N.; Cheli, F.; Avantaggiato, G.; Greco, D.; Đuragić, O.; Kos, J.; Pinotti, L. Decontamination of Mycotoxin-Contaminated Feedstuffs and Compound Feed. Toxins 2019, 11, 617. [Google Scholar] [CrossRef]
- Bubici, G.; Kaushal, M.; Prigigallo, M.I.; Cabanás, C.G.L.; Mercado-Blanco, J. Biological control agents against Fusarium wilt of banana. Front. Microbiol. 2019, 10, 616. [Google Scholar] [CrossRef]
- Singh, P.; Pandey, A.K. Prospective of essential oils of the genus mentha as biopesticides: A review. Front. Plant Sci. 2018, 9, 1295. [Google Scholar] [CrossRef] [PubMed]
- Massoud, M.A.; Saad, A.S.A.; Soliman, E.A.; El-Moghazy, A.Y. Antifungal activity of some essential oils applied as fumigants against two stored grains fungi. J. Adv. Agric. Res. 2012, 17, 296–306. [Google Scholar]
- Kowalska, J.; Tyburski, J.; Krzymińska, J.; Jakubowska, M. Cinnamon powder: An in vitro and in vivo evaluation of antifungal and plant growth promoting activity. Eur. J. Plant Pathol. 2020, 156, 237–243. [Google Scholar] [CrossRef]
- Wu, D.; Lu, J.; Zhong, S.; Schwarz, P.; Chen, B.; Rao, J. Influence of nonionic and ionic surfactants on the antifungal and mycotoxin inhibitory efficacy of cinnamon oil nanoemulsions. Food Funct. 2019, 10, 2817–2827. [Google Scholar] [CrossRef] [PubMed]
- Rafiee, H.; Mehrafarin, A.; Omidi, H.; Badi, H.N.; Khalighi-Sigaroodi, F. Evaluation of Phytochemical and Biochemical Patterns of Lemon Verbena (Lippia citriodora H.B.K.) at Different Temperatures. Res. J. Pharmacogn. 2019, 6, 9–24. [Google Scholar] [CrossRef]
- Hosseini, M.; Jamshidi, A.; Raeisi, M.; Azizzadeh, M. The Antibacterial and Antioxidant Effects of Clove (Syzygium aromaticum) and Lemon Verbena (Aloysia citriodora) Essential Oils. J. Hum. Environ. Health Promot. 2019, 5, 86–93. [Google Scholar] [CrossRef]
- Krzyśko-Łupicka, T.; Sokół, S.; Piekarska-Stachowiak, A. Evaluation of Fungistatic Activity of Eight Selected Essential Oils on Four Heterogeneous Fusarium Isolates Obtained from Cereal Grains in Southern Poland. Molecules 2020, 25, 292. [Google Scholar] [CrossRef]
- da Silva Franca, K.R.; dos Santos, X.A.L.; de Alves, F.M.F.; Lima, T.S.; de Araújo, I.G.; da Nóbrega, L.P. Control of Fusarium verticillioides using Palmarosa Essential Oil (Cymbopogon martinii) Maracajá View project Ecology of waterbirds in semi-arid lands View project. Artic. Int. J. Curr. Microbiol. Appl. Sci. 2019, 8, 484–494. [Google Scholar] [CrossRef]
- Wan, J.; Zhong, S.; Schwarz, P.; Chen, B.; Rao, J. Physical properties, antifungal and mycotoxin inhibitory activities of five essential oil nanoemulsions: Impact of oil compositions and processing parameters. Food Chem. 2019, 291, 199–206. [Google Scholar] [CrossRef] [PubMed]
- Olosunde, O.O.; Adegoke, G.O.; Abiodun, O.A. Composition of sorghum-millet flour, Aframomum danielli essential oil and their effect on mycotoxins in kunu zaki. Afr. J. Food Sci. 2015, 9, 411–416. [Google Scholar] [CrossRef][Green Version]
- Sumalan, R.N.; Ersilia, A.; Mariana, A.P. Assessment of inhibitory potential of essential oils on natural mycoflora and fusarium mycotoxins production in wheat. Chem. Cent. J. 2013, 7, 32. [Google Scholar] [CrossRef]
- da Silva Bomfim, N.; Kohiyama, C.Y.; Nakasugi, L.P.; Nerilo, S.B.; Mossini, S.A.G.; Romoli, J.C.Z.; Mikcha, J.M.G.; de Abreu Filho, B.A.; Machinski, M., Jr. Antifungal and antiaflatoxigenic activity of rosemary essential oil (Rosmarinus officinalis L.) against Aspergillus flavus. Food Addit. Contam. Part A 2020, 37, 153–161. [Google Scholar] [CrossRef]
- Rasooli, I.; Owlia, P. Chemoprevention by thyme oils of Aspergillus parasiticus growth and aflatoxin production. Phytochemistry 2005, 66, 2851–2856. [Google Scholar] [CrossRef]
- Tian, J.; Huang, B.; Luo, X.; Zeng, H.; Ban, X.; He, J.; Wang, Y. The control of Aspergillus flavus with Cinnamomun jensenianum hand.—Mazz essential oil and its potential use as a food preservative. Food Chem. 2012, 130, 520–527. [Google Scholar] [CrossRef]
- Ferreira, F.D.; Kemmelmeier, C.; Arroteia, C.C.; Costa, C.L.; Mallmann, C.A.; Janeiro, V.; Ferreira, F.M.D.; Mossini, S.A.G.; Silva, E.L.; Machinski, M., Jr. Inhibitory effect of the essential oil of Curcuma longa L. and curcumin on aflatoxin production by Aspergillus flavus link. Food Chem. 2013, 136, 789–793. [Google Scholar] [CrossRef]
- Kessel, G.J.T.; de Hass, B.H.; Lombaers-van der Plas, C.H.; Meijer, E.M.J.; Dewey, F.M.; Gou-driaan, J.; ven der Werf, W.; Kohl, J. Quantification of mycelium of Botrytis spp. and the antagonist Ulocladium atrum in necrotic leaf tissue of Cyclamen and Lily by fluorescence microscopy and image analysis. Phytopathology 1999, 89, 868–876. [Google Scholar] [CrossRef]
- Foglieni, C.; Meoni, C.; Davalli, A.M. Fluorescent dyes for cell viability: An application on prefixed condition. Histochem. Cell Biol. 2001, 115, 223–229. [Google Scholar] [CrossRef]
- Khan, M.M.T.; Pyle, B.H.; Camper, A.K. Specific and rapid enumeration of viable but nonculturable and viable-culturable gram-negative bacteria by using flow cytometry. Appl. Environ. Microbiol. 2010, 76, 5088–5096. [Google Scholar] [CrossRef]
- Fernandez-Miranda, E.; Majada, J.; Casares, A. Efficacy of propidium iodide and FUN-1 stains for assessing viability in basidiospores of Rhizopogon roseolus. Mycologia 2017, 109, 350–358. [Google Scholar] [CrossRef]
- Li, X.; Quan, C.S.; Yu, H.Y.; Wang, J.H.; Fan, S.D. Assessment of an-tifungal effects of a novel compound from Burkholderia cepacia against Fusarium solani by fluorescent staining. World J. Microbiol. Biotechnol. 2009, 25, 151–154. [Google Scholar] [CrossRef]
- Kim, J.; Le, K.D.; Yu, N.H.; Kim, J.I.; Kim, J.C.; Lee, C.W. Structure and antifungal activity of pelgipeptins from Paenibacillus elgii against phytopathogenic fungi. Pestic. Biochem. Physiol. 2020, 163, 154–163. [Google Scholar] [CrossRef] [PubMed]
- Suhr, K.I.; Nielsen, P.V. Antifungal activity of essential oils evaluated by two different application techniques against rye bread spoilage fungi. J. Appl. Microbiol. 2003, 94, 665–674. [Google Scholar] [CrossRef] [PubMed]
- Arras, G.; Usai, M. Fungitoxic activity of 12 essential oils against four postharvest citrus pathogens: Chemical analysis of Thymus capitatus oil and its effect in subatmospheric pressure conditions. J. Food Prot. 2001, 64, 1025–1029. [Google Scholar] [CrossRef] [PubMed]
- Ultee, A.; Smid, E.J. Influence of Carvacrol on growth and toxin pro-duction by Bacillus cereus. Int. J. Food Microbiol. 2001, 64, 373–378. [Google Scholar] [CrossRef]

| EO | Effects of Different EO Concentrations on Mycelium Growth | |||||||
|---|---|---|---|---|---|---|---|---|
| 0.1% | 1.0% | 5.0% | 10.0% | |||||
| Mycelium Size [mm] | Growth Reduction [%] | Mycelium Size [mm] | Growth Reduction [%] | Mycelium Size [mm] | Growth Reduction [%] | Mycelium Size [mm] | Growth Reduction [%] | |
| Cinnamon | 50.00 ± 0.00 | 0 | 50.00 ± 0.00 | 0 | 10.50 ± 6.36 | 90 | 6.00 ± 0.00 | 100 |
| Verbena | 50.00 ± 0.00 | 0 | 48.00 ± 1.41 | 5 | 20.00 ± 7.07 | 68 | 6.00 ± 0.00 | 100 |
| Palmarosa | 50.00 ± 0.00 | 0 | 50.00 ± 0.00 | 0 | 49.75 ± 0.35 | 1 | 47.75 ± 1.77 | 5 |
Publisher’s Note: MDPI stays neutral with regard to jurisdictional claims in published maps and institutional affiliations. |
© 2022 by the authors. Licensee MDPI, Basel, Switzerland. This article is an open access article distributed under the terms and conditions of the Creative Commons Attribution (CC BY) license (https://creativecommons.org/licenses/by/4.0/).
Share and Cite
Gwiazdowska, D.; Marchwińska, K.; Juś, K.; Uwineza, P.A.; Gwiazdowski, R.; Waśkiewicz, A.; Kierzek, R. The Concentration-Dependent Effects of Essential Oils on the Growth of Fusarium graminearum and Mycotoxins Biosynthesis in Wheat and Maize Grain. Appl. Sci. 2022, 12, 473. https://doi.org/10.3390/app12010473
Gwiazdowska D, Marchwińska K, Juś K, Uwineza PA, Gwiazdowski R, Waśkiewicz A, Kierzek R. The Concentration-Dependent Effects of Essential Oils on the Growth of Fusarium graminearum and Mycotoxins Biosynthesis in Wheat and Maize Grain. Applied Sciences. 2022; 12(1):473. https://doi.org/10.3390/app12010473
Chicago/Turabian StyleGwiazdowska, Daniela, Katarzyna Marchwińska, Krzysztof Juś, Pascaline Aimee Uwineza, Romuald Gwiazdowski, Agnieszka Waśkiewicz, and Roman Kierzek. 2022. "The Concentration-Dependent Effects of Essential Oils on the Growth of Fusarium graminearum and Mycotoxins Biosynthesis in Wheat and Maize Grain" Applied Sciences 12, no. 1: 473. https://doi.org/10.3390/app12010473
APA StyleGwiazdowska, D., Marchwińska, K., Juś, K., Uwineza, P. A., Gwiazdowski, R., Waśkiewicz, A., & Kierzek, R. (2022). The Concentration-Dependent Effects of Essential Oils on the Growth of Fusarium graminearum and Mycotoxins Biosynthesis in Wheat and Maize Grain. Applied Sciences, 12(1), 473. https://doi.org/10.3390/app12010473

